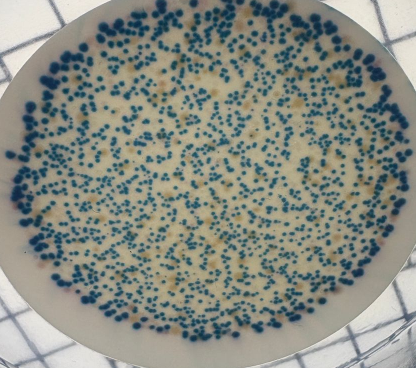
Raju Roy tweet media

Sabitlenmiş Tweet

Did you know there is a factor regulating P-body disassembly? Our recent article published @NatureComms, highlights the role of an IDR containing protein in P-body disassembly. Curious!!😀 Check the link nature.com/articles/s4146…
@iiscbangalore @rajgodhuli @LabRajyaguru
English